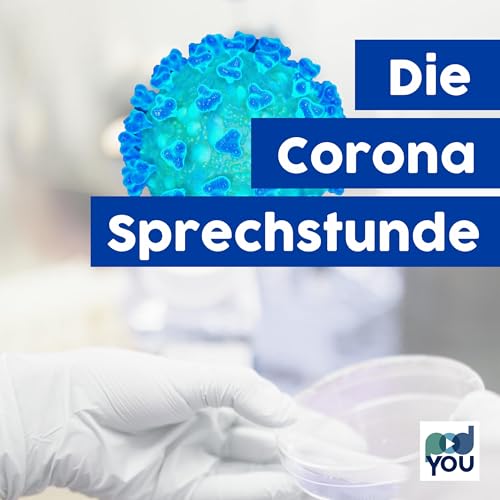
Die Corona Sprechstunde Podcast Por PodYou arte de portada

Mostrando resultados por autor "PodYou" en Todas las categorías
-
-
UTN Explorer – der Podcast der Technischen Universität Nürnberg
- De: PodYou
- Grabación Original
-
General0
-
Narración:0
-
Historia0
Taucht ein in die Wissenschaft und Lehre der Zukunft! Begleitet uns auf eine Expedition durch den Aufbau der UTN – der ersten staatlichen Neugründung einer Universität in Bayern seit über 40 Jahren. Erlebt, wie sich unser wissenschaftlicher Fokus entwickelt, wie zukunftsweisende Studiengänge entstehen und seid dabei, wenn ein innovativer Campus wächst. UTN Explorer: Deine Reise in die Zukunft beginnt hier!
No se pudo agregar al carrito
Solo puedes tener X títulos en el carrito para realizar el pago.Add to Cart failed.
Por favor prueba de nuevo más tardeError al Agregar a Lista de Deseos.
Por favor prueba de nuevo más tardeError al eliminar de la lista de deseos.
Por favor prueba de nuevo más tardeError al añadir a tu biblioteca
Por favor intenta de nuevoError al seguir el podcast
Intenta nuevamenteError al dejar de seguir el podcast
Intenta nuevamente -
-
-
Ethik und Medizin am Klinikum Nürnberg
- De: PodYou
- Grabación Original
-
General0
-
Narración:0
-
Historia0
Über 100.000 Menschen bekommen jedes Jahr medizinische Versorgung am Klinikum Nürnberg. Klar, dass dort gut ausgebildete Spezialisten arbeiten. Aber die Profis am Klinikum machen sich auch Gedanken über die reine medizinische Lehre hinaus. Darüber berichtet dieser Podcast in insgesamt fünf Folgen.
No se pudo agregar al carrito
Solo puedes tener X títulos en el carrito para realizar el pago.Add to Cart failed.
Por favor prueba de nuevo más tardeError al Agregar a Lista de Deseos.
Por favor prueba de nuevo más tardeError al eliminar de la lista de deseos.
Por favor prueba de nuevo más tardeError al añadir a tu biblioteca
Por favor intenta de nuevoError al seguir el podcast
Intenta nuevamenteError al dejar de seguir el podcast
Intenta nuevamente -
-
-
Geschichten aus dem Sarg
- De: PodYou
- Grabación Original
-
General0
-
Narración:0
-
Historia0
Was passiert, wenn ich sterbe? Welche Bestattungsformen gibt es? Muss ich Angst vor dem Sterben und dem Tod haben? In diesem Podcast erzählt Bestatter Lorenz Häusler von Bestattungen Häusler aus Neumarkt in der Oberpfalz über seinen Job, seine Lebensphilosophie und seinen Alltag. Und das alles in einem ungewöhnlich spannenden Setting: auf dem St. Johannisfriedhof in Nürnberg. Und vielleicht sind es die Geister der Verstorbenen, oder die wunderschönen Gräber: Lorenz Häusler schafft es den Tod zum normalsten Teil des Lebens zu machen... Hören Sie selbst.
No se pudo agregar al carrito
Solo puedes tener X títulos en el carrito para realizar el pago.Add to Cart failed.
Por favor prueba de nuevo más tardeError al Agregar a Lista de Deseos.
Por favor prueba de nuevo más tardeError al eliminar de la lista de deseos.
Por favor prueba de nuevo más tardeError al añadir a tu biblioteca
Por favor intenta de nuevoError al seguir el podcast
Intenta nuevamenteError al dejar de seguir el podcast
Intenta nuevamente -
-
-
Schulterblick
- De: PodYou
- Grabación Original
-
General0
-
Narración:0
-
Historia0
Von rückwärts einparken, über den Busführerschein bis hin zur Ausbildung zum Fahrlehrer. Im Podcast "Schulterblick" entführen Sie der Radio-Verkehrsexperte Jörg Dippold und Jürgen Schielein, Inhaber des Verkehrsinstituts Schielein in Nürnberg, in die Welt der Fahrschule.
No se pudo agregar al carrito
Solo puedes tener X títulos en el carrito para realizar el pago.Add to Cart failed.
Por favor prueba de nuevo más tardeError al Agregar a Lista de Deseos.
Por favor prueba de nuevo más tardeError al eliminar de la lista de deseos.
Por favor prueba de nuevo más tardeError al añadir a tu biblioteca
Por favor intenta de nuevoError al seguir el podcast
Intenta nuevamenteError al dejar de seguir el podcast
Intenta nuevamente -
-
-
Sterben Leicht Gemacht
- De: PodYou
- Grabación Original
-
General0
-
Narración:0
-
Historia0
Im Podcast des „Hospiz-Team Nürnberg“ spricht Günther Moosberger offen und ohne Tabus mit den Mitarbeiterinnen und Mitarbeitern des Hospizteams über unsere letzten Tage und Stunden. Ignorieren und Verschweigen war gestern. Hier gibt es Begleitung und Beratung für unheilbar Kranke, Sterbende, Angehörige und trauernde Menschen.
No se pudo agregar al carrito
Solo puedes tener X títulos en el carrito para realizar el pago.Add to Cart failed.
Por favor prueba de nuevo más tardeError al Agregar a Lista de Deseos.
Por favor prueba de nuevo más tardeError al eliminar de la lista de deseos.
Por favor prueba de nuevo más tardeError al añadir a tu biblioteca
Por favor intenta de nuevoError al seguir el podcast
Intenta nuevamenteError al dejar de seguir el podcast
Intenta nuevamente -
-
-
Zwei hinreißend verdorbene Franken
- De: PodYou
- Grabación Original
-
General0
-
Narración:0
-
Historia0
Der Nürnberger Bestseller-Autor Andi Hock und der Fürther Komödiant Marcel Gasde sind "Zwei hinreißend verdorbene Franken". In unnachahmlich unkorrekter Art kommentieren die beiden das aktuelle Geschehen in der Region und der Welt mit fundiertem Halbwissen, jeder Menge Witz und einer ordentlichen Prise Sarkasmus. Garantiert nichts für Feingeister, aber gnadenlos komisch!
No se pudo agregar al carrito
Solo puedes tener X títulos en el carrito para realizar el pago.Add to Cart failed.
Por favor prueba de nuevo más tardeError al Agregar a Lista de Deseos.
Por favor prueba de nuevo más tardeError al eliminar de la lista de deseos.
Por favor prueba de nuevo más tardeError al añadir a tu biblioteca
Por favor intenta de nuevoError al seguir el podcast
Intenta nuevamenteError al dejar de seguir el podcast
Intenta nuevamente -
-
-
Immobilien & Vermögen – der Noble Home Invest Podcast
- De: PodYou
- Grabación Original
-
General0
-
Narración:0
-
Historia0
Noble Home Invest, der fränkische Partner für Immobilien, Vermögensberatung und Sale Lease Back, informiert Sie hier über seine Arbeit.Noble Home Invest GmbH • Hirschenstr. 38 • 90762 Fürth • 📞0911 - 25580668 • info@noblehome-invest.de
No se pudo agregar al carrito
Solo puedes tener X títulos en el carrito para realizar el pago.Add to Cart failed.
Por favor prueba de nuevo más tardeError al Agregar a Lista de Deseos.
Por favor prueba de nuevo más tardeError al eliminar de la lista de deseos.
Por favor prueba de nuevo más tardeError al añadir a tu biblioteca
Por favor intenta de nuevoError al seguir el podcast
Intenta nuevamenteError al dejar de seguir el podcast
Intenta nuevamente -
-
-
beauty4u
- De: PodYou
- Grabación Original
-
General0
-
Narración:0
-
Historia0
beauty4u - für dein neues Lebensgefühl mit dem Ästhetik Team NürnbergWir als Ästhetik Team Nürnberg kümmern uns um dein Wohlbefinden. Von Brust-OPs, über Falten- und Lippenbehandlungen, bis hin zu Körperstraffungen oder Gesichtsverjüngung - in unserem Podcast klären wir dich auf und liefern Antworten rund um das Thema Schönheitschirurgie.Außerdem geben wir exklusive Einblicke in die Arbeit einer Privatklinik für Plastische und Ästhetische Chirurgie. Kompetent und ehrlich - das ist Nürnbergs erster Beauty-Podcast rund um das Thema Schönheits-OPs.Für dich - für dein neues ...
No se pudo agregar al carrito
Solo puedes tener X títulos en el carrito para realizar el pago.Add to Cart failed.
Por favor prueba de nuevo más tardeError al Agregar a Lista de Deseos.
Por favor prueba de nuevo más tardeError al eliminar de la lista de deseos.
Por favor prueba de nuevo más tardeError al añadir a tu biblioteca
Por favor intenta de nuevoError al seguir el podcast
Intenta nuevamenteError al dejar de seguir el podcast
Intenta nuevamente -
-
No se pudo agregar al carrito
Solo puedes tener X títulos en el carrito para realizar el pago.Add to Cart failed.
Por favor prueba de nuevo más tardeError al Agregar a Lista de Deseos.
Por favor prueba de nuevo más tardeError al eliminar de la lista de deseos.
Por favor prueba de nuevo más tardeError al añadir a tu biblioteca
Por favor intenta de nuevoError al seguir el podcast
Intenta nuevamenteError al dejar de seguir el podcast
Intenta nuevamente -
-
Beas Horoskop - der verrückte Blick in die Sterne
- De: PodYou
- Grabación Original
-
General0
-
Narración:0
-
Historia0
Showproducer Marvin Fleischmann aus der Flo Kerschner Show schlüpft in die Rolle einer holländischen Astrologin und schaut für ganz Franken in die Glaskugel! Lustig, frech und definitiv kein normales Horoskop. Bea soll auch für euch in die Sterne schauen? Schickt uns eine Sprachnachricht mit eurem Sternzeichen an die 0800 929 0929!
No se pudo agregar al carrito
Solo puedes tener X títulos en el carrito para realizar el pago.Add to Cart failed.
Por favor prueba de nuevo más tardeError al Agregar a Lista de Deseos.
Por favor prueba de nuevo más tardeError al eliminar de la lista de deseos.
Por favor prueba de nuevo más tardeError al añadir a tu biblioteca
Por favor intenta de nuevoError al seguir el podcast
Intenta nuevamenteError al dejar de seguir el podcast
Intenta nuevamente -
-
-
Die Zukunft spricht - Der Podcast aus dem Nürnberger Zukunftsmuseum
- De: PodYou
- Grabación Original
-
General0
-
Narración:0
-
Historia0
Einblicke in Nürnbergs neustes und spektakulärstes Museum.Hier erwartet Euch die Zukunft. Ein neues Haus, ein neues Thema und viele neue neue Objekte: Seit 18. September 2021 stehen die Türen des Zukunftsmuseums allen Besucherinnen und Besuchern offen. Im Herzen der Nürnberger Altstadt lädt die neue Zweigstelle des Deutschen Museums zu einem spannenden und aufschlussreichen Blick auf die Entwicklung von Technik und Gesellschaft. In unserem Podcast trifft Stefan Grundler die Macherinnen und Macher des Deutschen Museums Nürnberg. Sie erklären unter anderem Wissenswertes über das Museum ...
No se pudo agregar al carrito
Solo puedes tener X títulos en el carrito para realizar el pago.Add to Cart failed.
Por favor prueba de nuevo más tardeError al Agregar a Lista de Deseos.
Por favor prueba de nuevo más tardeError al eliminar de la lista de deseos.
Por favor prueba de nuevo más tardeError al añadir a tu biblioteca
Por favor intenta de nuevoError al seguir el podcast
Intenta nuevamenteError al dejar de seguir el podcast
Intenta nuevamente -
-
-
Stadt-Gespräch | Der Podcast für Nürnberg
- De: PodYou
- Grabación Original
-
General0
-
Narración:0
-
Historia0
Einblicke in die Schaltzentrale unserer Metropole!Über eine halbe Million Menschen wohnen in Nürnberg. Ihr Zusammenleben wird im Rathaus organisiert. Aber was geschieht eigentlich hinter den Mauern am Hauptmarkt? Wie arbeiten die verschiedenen Referate und auch das Parlament, der Stadtrat? Wer sind eigentlich die Menschen, die in unserer Stadt das Sagen haben und was machen sie in ihrer Freizeit? Darüber informieren wir Euch im Stadt-Gespräch. Referenten, Mitarbeiter und der Oberbürgermeister geben Einblicke in ihre Arbeit und berichten über ihre Pläne, mit denen sie Nürnberg noch ...
No se pudo agregar al carrito
Solo puedes tener X títulos en el carrito para realizar el pago.Add to Cart failed.
Por favor prueba de nuevo más tardeError al Agregar a Lista de Deseos.
Por favor prueba de nuevo más tardeError al eliminar de la lista de deseos.
Por favor prueba de nuevo más tardeError al añadir a tu biblioteca
Por favor intenta de nuevoError al seguir el podcast
Intenta nuevamenteError al dejar de seguir el podcast
Intenta nuevamente -
-
-
Stilvoll feiern - Jägers Gwächshaus Podcast
- De: PodYou
- Grabación Original
-
General0
-
Narración:0
-
Historia0
Heiraten vor einem romantischen Sonnenuntergang, leckeres Team-Kochen oder Dinner im Dunkeln - In Jägers Gwächshaus im Nürnberger Knoblauchsland werden Träume wahr! Was alles möglich ist und Tipps für eine unvergessliche Feier, gibt es hier in diesem Podcast.
No se pudo agregar al carrito
Solo puedes tener X títulos en el carrito para realizar el pago.Add to Cart failed.
Por favor prueba de nuevo más tardeError al Agregar a Lista de Deseos.
Por favor prueba de nuevo más tardeError al eliminar de la lista de deseos.
Por favor prueba de nuevo más tardeError al añadir a tu biblioteca
Por favor intenta de nuevoError al seguir el podcast
Intenta nuevamenteError al dejar de seguir el podcast
Intenta nuevamente -
-
-
Stadtgrenzler - Der Nürnberg-Fürth-Podcast mit Andreas Hock und Marcel Gasde
- De: PodYou
- Grabación Original
-
General0
-
Narración:0
-
Historia0
Zwei Städte, zwei Männer, zwei Meinungen, ein Humor: Noch nie war die Rivalität zwischen den beiden fränkischen Nachbarn so lustig wie bei Andi Hock und Marcel Gasde. Wenn der Nürnberger Bestsellerautor und Club-Fan auf den Kleeblatt-Anhänger und Geschäftsführer der Fürther Comödie trifft, wird es kontrovers, kurios und komisch. Gesellschaftliche relevante Themen, kulturelle Entwicklungen, weltpolitische Zusammenhänge - das sucht man hier vergebens. Stattdessen wird alles kommentiert, was BILD-Zeitung, RTL2 und die Sportschau hergeben... Das ist niederschwelliges Diskussionsniveau ...
No se pudo agregar al carrito
Solo puedes tener X títulos en el carrito para realizar el pago.Add to Cart failed.
Por favor prueba de nuevo más tardeError al Agregar a Lista de Deseos.
Por favor prueba de nuevo más tardeError al eliminar de la lista de deseos.
Por favor prueba de nuevo más tardeError al añadir a tu biblioteca
Por favor intenta de nuevoError al seguir el podcast
Intenta nuevamenteError al dejar de seguir el podcast
Intenta nuevamente -
-
-
VIELFALT - DER CSD PODCAST
- De: PodYou
- Grabación Original
-
General0
-
Narración:0
-
Historia0
Herzlich willkommen beim Podcast des CSD NÜRNBERG PRIDE. Wir geben euch hier Einblicke in aktuelle Themen rund um Queerness und den CSD NÜRNBERG selbst. Viel Spaß beim Hören.Gemeinsam kämpfen wir in Gesellschaft und Politik unter der Devise „LGBTQIA+ = MENSCH“ / für Unterstützung der queeren Community/ für Freiheit und gleiche Rechte/ gegen Homo-, Bi-, Inter- und Transphobie/ gegen jegliche Queerfeindlichkeit/ gegen jegliche Diskriminierung/ in Nürnberg, Bayern, Deutschland und Europa
No se pudo agregar al carrito
Solo puedes tener X títulos en el carrito para realizar el pago.Add to Cart failed.
Por favor prueba de nuevo más tardeError al Agregar a Lista de Deseos.
Por favor prueba de nuevo más tardeError al eliminar de la lista de deseos.
Por favor prueba de nuevo más tardeError al añadir a tu biblioteca
Por favor intenta de nuevoError al seguir el podcast
Intenta nuevamenteError al dejar de seguir el podcast
Intenta nuevamente -
-
No se pudo agregar al carrito
Solo puedes tener X títulos en el carrito para realizar el pago.Add to Cart failed.
Por favor prueba de nuevo más tardeError al Agregar a Lista de Deseos.
Por favor prueba de nuevo más tardeError al eliminar de la lista de deseos.
Por favor prueba de nuevo más tardeError al añadir a tu biblioteca
Por favor intenta de nuevoError al seguir el podcast
Intenta nuevamenteError al dejar de seguir el podcast
Intenta nuevamente -
-
Medaillentraum - Der Podcast mit Nürnbergs Olympia-Hoffnungen
- De: PodYou
- Grabación Original
-
General0
-
Narración:0
-
Historia0
Elf Nürnberger Athleten, ein gemeinsamer Traum: Die deutschen Farben bei Olympischen und Paralympischen Spielen vertreten. Die Athleten des GOLDENEN RING sind Welt- und Europameister. Im Taekwondo, Schwimmen, Paracycling oder Goalball gehören sie zur Weltspitze. Trotzdem verlaufen ihre Ausnahmekarrieren im Schatten der kommerziellen Sportarten. Im Gespräch mit N1 Morgenmoderator Flo Kerschner erzählen echte Local Heros aus dem Nürnberger Sport ihre persönliche Geschichte und geben spannende Einblicke in ihre Karrieren.
No se pudo agregar al carrito
Solo puedes tener X títulos en el carrito para realizar el pago.Add to Cart failed.
Por favor prueba de nuevo más tardeError al Agregar a Lista de Deseos.
Por favor prueba de nuevo más tardeError al eliminar de la lista de deseos.
Por favor prueba de nuevo más tardeError al añadir a tu biblioteca
Por favor intenta de nuevoError al seguir el podcast
Intenta nuevamenteError al dejar de seguir el podcast
Intenta nuevamente -
-
No se pudo agregar al carrito
Solo puedes tener X títulos en el carrito para realizar el pago.Add to Cart failed.
Por favor prueba de nuevo más tardeError al Agregar a Lista de Deseos.
Por favor prueba de nuevo más tardeError al eliminar de la lista de deseos.
Por favor prueba de nuevo más tardeError al añadir a tu biblioteca
Por favor intenta de nuevoError al seguir el podcast
Intenta nuevamenteError al dejar de seguir el podcast
Intenta nuevamente -
-
Sterben heißt Leben bis zum Schluss
- De: PodYou
- Grabación Original
-
General0
-
Narración:0
-
Historia0
In diesem Podcast sprechen wir ohne Tabus über die Unterstützungsmöglichkeiten und die Arbeit des ambulanten Hospizverein Schwabach e.V. Wie begleiten Ehrenamtliche und Fachkräfte Menschen am Lebensende? Was bedeutet würdevolle Begleitung und wie finden Angehörige Halt in ihrer Trauer? Mit persönlichen Geschichten und fachlicher Kompetenz zeigen wir, dass Sterben immer noch Leben bedeutet – bis zum letzten Moment.
No se pudo agregar al carrito
Solo puedes tener X títulos en el carrito para realizar el pago.Add to Cart failed.
Por favor prueba de nuevo más tardeError al Agregar a Lista de Deseos.
Por favor prueba de nuevo más tardeError al eliminar de la lista de deseos.
Por favor prueba de nuevo más tardeError al añadir a tu biblioteca
Por favor intenta de nuevoError al seguir el podcast
Intenta nuevamenteError al dejar de seguir el podcast
Intenta nuevamente -
-
El Poder De La Mente Subconsciente [The Power of the Subconscious Mind]
- De: Joseph Murphy
- Narrado por: Marcelo Russo
- Duración: 9 h y 27 m
- Versión completa
-
General672
-
Narración:651
-
Historia651
El poder de la mente subconsciente es un libro de autoayuda publicado por primera vez en 1963 por el autor Joseph Murphy. El libro sostiene que la mente subconsciente es una fuente de poder ilimitado que puede utilizarse para lograr cualquier objetivo.
-
-
control de la mente subconsciente
- De LUIS A SALAZAR ORDAZ en 12-01-25
De: Joseph Murphy
-
Hábitos atómicos (Español neutro)
- Un método sencillo y comprobado para desarrollar buenos hábitos y eliminar los malos
- De: James Clear
- Narrado por: Arturo Guerrero
- Duración: 9 h y 1 m
- Versión completa
-
General4,897
-
Narración:4,127
-
Historia4,125
James Clear nos brinda fantásticas ideas basadas en investigaciones científicas, que le permiten revelarnos cómo podemos transformar pequeños hábitos cotidianos para cambiar nuestra vida y mejorarla. Esta guía pone al descubierto las fuerzas ocultas que moldean nuestro comportamiento - desde nuestra mentalidad, pasando por el ambiente y hasta la genética - y nos demuestra cómo aplicar cada cambio a nuestra vida y a nuestro trabajo. Después de leer este libro, tendrás un método sencillo para desarrollar un sistema eficaz que te conducirá al éxito.
-
-
Hábitos atómicos
- De Anónimo en 17-07-22
De: James Clear
-
La psicología del dinero
- Cómo piensan los ricos: 18 claves imperecederas sobre riqueza y felicidad
- De: Morgan Housel, Arnau Figueras Deulofeu (traductor)
- Narrado por: Miguel Coll
- Duración: 7 h y 2 m
- Versión completa
-
General915
-
Narración:837
-
Historia837
En cuestiones de dinero, lo que importa no es lo listo que seas sino cómo te comportas. Tendemos a pensar en la inversión o la gestión de las finanzas personales como una disciplina matemática, en la que los datos y las fórmulas nos dicen exactamente qué hacer. Sin embargo, el rasgo que define a las personas que logran enriquecerse no es su destreza con los números, ni su salario o su talento, sino su historia personal, sus motivaciones y su visión única del mundo.
-
-
Excelente
- De Carlos Varela en 09-02-24
De: Morgan Housel, y otros
-
Los secretos de la mente millonaria (Narración en Castellano) [Secrets of the Millionaire Mind]
- Domina el juego de la riqueza [Mastering the Inner Game of Wealth]
- De: T. Harv Eker
- Narrado por: Ivan Villanueva
- Duración: 2 h y 17 m
- Versión completa
-
General1,233
-
Narración:1,142
-
Historia1,146
El autor estaba en bancarrota, en solo dos años y medio se convirtió en millonario y construyó una de las más grandes firmas de consultoría para el éxito. Con sus enseñanzas ha tocado la vida de millones de personas. Este audiolibro te enseña a observar como piensas. Es un reto a tus ideas que te limitan, a los razonamientos que no te apoyan y a tus acciones con respecto al dinero.
-
-
El libro está bien, pero ES VERSION RESUMIDA
- De alexnvlp en 24-08-23
De: T. Harv Eker
-
El Poder De La Mente Subconsciente [The Power of the Subconscious Mind]
- De: Joseph Murphy
- Narrado por: Marcelo Russo
- Duración: 9 h y 27 m
- Versión completa
-
General672
-
Narración:651
-
Historia651
El poder de la mente subconsciente es un libro de autoayuda publicado por primera vez en 1963 por el autor Joseph Murphy. El libro sostiene que la mente subconsciente es una fuente de poder ilimitado que puede utilizarse para lograr cualquier objetivo.
-
-
control de la mente subconsciente
- De LUIS A SALAZAR ORDAZ en 12-01-25
De: Joseph Murphy
-
Hábitos atómicos (Español neutro)
- Un método sencillo y comprobado para desarrollar buenos hábitos y eliminar los malos
- De: James Clear
- Narrado por: Arturo Guerrero
- Duración: 9 h y 1 m
- Versión completa
-
General4,897
-
Narración:4,127
-
Historia4,125
James Clear nos brinda fantásticas ideas basadas en investigaciones científicas, que le permiten revelarnos cómo podemos transformar pequeños hábitos cotidianos para cambiar nuestra vida y mejorarla. Esta guía pone al descubierto las fuerzas ocultas que moldean nuestro comportamiento - desde nuestra mentalidad, pasando por el ambiente y hasta la genética - y nos demuestra cómo aplicar cada cambio a nuestra vida y a nuestro trabajo. Después de leer este libro, tendrás un método sencillo para desarrollar un sistema eficaz que te conducirá al éxito.
-
-
Hábitos atómicos
- De Anónimo en 17-07-22
De: James Clear
-
La psicología del dinero
- Cómo piensan los ricos: 18 claves imperecederas sobre riqueza y felicidad
- De: Morgan Housel, Arnau Figueras Deulofeu (traductor)
- Narrado por: Miguel Coll
- Duración: 7 h y 2 m
- Versión completa
-
General915
-
Narración:837
-
Historia837
En cuestiones de dinero, lo que importa no es lo listo que seas sino cómo te comportas. Tendemos a pensar en la inversión o la gestión de las finanzas personales como una disciplina matemática, en la que los datos y las fórmulas nos dicen exactamente qué hacer. Sin embargo, el rasgo que define a las personas que logran enriquecerse no es su destreza con los números, ni su salario o su talento, sino su historia personal, sus motivaciones y su visión única del mundo.
-
-
Excelente
- De Carlos Varela en 09-02-24
De: Morgan Housel, y otros
-
Los secretos de la mente millonaria (Narración en Castellano) [Secrets of the Millionaire Mind]
- Domina el juego de la riqueza [Mastering the Inner Game of Wealth]
- De: T. Harv Eker
- Narrado por: Ivan Villanueva
- Duración: 2 h y 17 m
- Versión completa
-
General1,233
-
Narración:1,142
-
Historia1,146
El autor estaba en bancarrota, en solo dos años y medio se convirtió en millonario y construyó una de las más grandes firmas de consultoría para el éxito. Con sus enseñanzas ha tocado la vida de millones de personas. Este audiolibro te enseña a observar como piensas. Es un reto a tus ideas que te limitan, a los razonamientos que no te apoyan y a tus acciones con respecto al dinero.
-
-
El libro está bien, pero ES VERSION RESUMIDA
- De alexnvlp en 24-08-23
De: T. Harv Eker
-
Proyecto Hail Mary [Project Hail Mary]
- De: Andy Weir, Javier Guerrero Gimeno
- Narrado por: Raúl Llorens
- Duración: 18 h y 23 m
- Versión completa
-
General1,129
-
Narración:1,062
-
Historia1,063
Proyecto Hail Mary, una aventura interestelar irresistible como solo Andy Weir podía imaginar, es una historia de descubrimiento, especulación y supervivencia a la altura de El marciano, que nos lleva a lugares que nunca soñamos alcanzar.
-
-
Genial
- De Mauricio en 01-10-22
De: Andy Weir, y otros
-
Recupera tu mente, reconquista tu vida
- De: Marian Rojas Estapé
- Narrado por: Teresa Fernández
- Duración: 12 h y 15 m
- Versión completa
-
General536
-
Narración:499
-
Historia499
Cómo rescatar la atención perdida en un mundo distraído e hiperconectado. Cada vez somos más impacientes y estamos más irritables. ¿Notas que te cuesta más prestar atención? ¿Has sentido ansiedad últimamente? ¿Toleras peor el aburrimiento y el dolor? Vivimos en la era de la gratificación instantánea, en la cultura de la inmediatez y las recompensas y buscamos la felicidad a golpe de clic. Llevamos una vida agitada e intensa, y con el modo fast activado. Sin darnos cuenta nos hemos convertido en drogodependientes emocionales inundados de múltiples distracciones.
-
-
está bien
- De Sonia E. Rosario Camilo en 31-05-24
-
El poder de la disciplina [The Power of Discipline]
- 7 pasos para alcanzar tus objetivos sin depender de tu motivación ni de tu fuerza de voluntad (Tu mejor versión) [7 Steps to Achieve Your Goals Without Depending on Your Motivation or Your Willpower (Your Best Version)]
- De: Daniel J. Martin
- Narrado por: Carlos Quintero
- Duración: 1 h y 58 m
- Versión completa
-
General410
-
Narración:401
-
Historia401
Perseguir nuestros objetivos es como emprender un viaje. Puede que la noche anterior te fueses a dormir temprano y que a la mañana siguiente cargases las pilas con un gran desayuno. Puede que incluso tengas un mapa detallado de adónde quieres ir. Pero una vez que te pones en marcha, sientes que el camino se va oscureciendo más y más a medida que avanzas. Hay tantas distracciones y obstáculos a lo largo de tu travesía que terminas perdiendo de vista el objetivo final.
-
-
Las enseñanzas
- De Flavia C. en 07-08-25
De: Daniel J. Martin
-
Cómo Abrazar a un Puercoespín
- Cómo Amar a las Personas Difíciles
- De: Sean Smith
- Narrado por: Martha Adriana Juárez
- Duración: 1 h y 24 m
- Versión completa
-
General161
-
Narración:158
-
Historia158
¡Descubre 101 estrategias de comunicación sencillas para tratar con personas difíciles —en casa, en el trabajo y en tu comunidad!
-
-
Entender y comprender con amor a otras personas.
- De Anónimo en 13-03-26
De: Sean Smith
-
Deja de ser tú
- De: Joe Dispenza
- Narrado por: Albert Cortés
- Duración: 11 h y 55 m
- Versión completa
-
General153
-
Narración:145
-
Historia145
Ahora, el popularísimo científico y autor de Desarrolla tu cerebro profundiza en todos aquellos temas que tanto nos cautivaron -física cuántica, neurociencia, biología y genética- para enseñarnos a reprogramar el cerebro y ampliar nuestro marco de realidad. El resultado es un método práctico de transformación para crear prosperidad y riqueza, pero también un viaje prodigioso a un nuevo estado de conciencia.
-
-
Yo creo lo bueno y lo malo en mi vida
- De Diego E Fernandez en 04-02-26
De: Joe Dispenza
-
Cómo hacer que te pasen cosas buenas
- Entiende tu cerebro, gestiona tus emociones, mejora tu vida
- De: Marián Rojas Estapé
- Narrado por: Valeria Arribas
- Duración: 7 h y 12 m
- Versión completa
-
General3,165
-
Narración:2,764
-
Historia2,764
Uniendo el punto de vista científico, psicológico y humano, la autora nos ofrece una reflexión profunda, salpicada de útiles consejos y con vocación eminentemente didáctica, acerca de la aplicación de nuestras propias capacidades al empeño de procurarnos una existencia plena y feliz: conocer y optimizar determinadas zonas del cerebro, fijar metas y objetivos en la vida, ejercitar la voluntad, poner en marcha la inteligencia emocional, desarrollar la asertividad, evitar el exceso de autocrítica y autoexigencia, reivindicar el papel del optimismo....
-
-
Superó mis expectativas
- De Anónimo en 11-10-20
-
Los cuatro acuerdos (Narración en Castellano) [The Four Agreements (Castilian Narration)]
- Una guía práctica para la libertad personal [A Practical Guide for Personal Freedom]
- De: Janet Mills, Don Miguel Ruiz
- Narrado por: David Albaladejo
- Duración: 2 h y 55 m
- Versión completa
-
General1,670
-
Narración:1,393
-
Historia1,396
El doctor Miguel Ruiz nos propone en este audiolibro un sencillo procedimiento para eliminar todas aquellas creencias heredadas que nos limitan y substituirlas por otras que responden a nuestra realidad interior y nos conducen a la libertad.
-
-
Decepción
- De berenice en 30-03-23
De: Janet Mills, y otros
-
Harry Potter y la piedra filosofal (Harry Potter 1)
- De: J.K. Rowling
- Narrado por: Carlos Ponce
- Duración: 8 h y 16 m
- Versión completa
-
General2,740
-
Narración:2,356
-
Historia2,342
Harry Potter jamás ha oído hablar de Hogwarts hasta que las cartas comienzan a llegar al número cuatro de Privet Drive, pero sus siniestros tíos se apropian rápidamente de estos pergaminos amarillentos que llevan la dirección escrita en tinta verde y un sello púrpura. Luego, en su undécimo cumpleaños, un gigantesco hombre con ojos como escarabajos llamado Rubeus Hagrid irrumpe con una noticia asombrosa: Harry Potter es un mago y lo esperan en el Colegio Hogwarts de Magia y Hechicería. ¡Una aventura increíble está por comenzar!
-
-
Excelente narración
- De Santiago del Solar en 05-03-19
De: J.K. Rowling
-
Cómo ganar amigos e influir sobre las personas [How to Win Friends and Influence People]
- De: Dale Carnegie
- Narrado por: Diego Guerrero
- Duración: 8 h y 42 m
- Versión completa
-
General1,993
-
Narración:1,596
-
Historia1,585
¿Qué pasos seguir para ganar popularidad y lograr que las personas hagan lo que uno desea? El reconocido método que presenta este audiolibro ofrece una respuesta con décadas de garantía.
-
-
me sorprendió woooow
- De Cliente de Kindle en 24-08-20
De: Dale Carnegie
-
Las 48 leyes del poder [The 48 Laws of Power]
- De: Robert Greene
- Narrado por: Ezequiel Alvarez
- Duración: 28 h y 13 m
- Versión completa
-
General85
-
Narración:81
-
Historia81
Amoral, inmisericorde, despiadada y, sobre todo, muy instructiva, esta incisiva obra concentra tres mil años de historia del poder en cuarenta y ocho leyes claras y concisas. Robert Greene detalla las leyes del poder en su esencia más cruda, sintetizando el pensamiento de Maquiavelo, Sun Tzu, Carl von Clausewitz y otros grandes teóricos y estrategas.
-
-
empezó mal alfinal me cambio
- De erick en 06-04-26
De: Robert Greene
-
Si lo crees, lo creas [Believe It to Achieve It]
- De: Brian Tracy, Christina Stein
- Narrado por: Dave Ramos
- Duración: 6 h y 6 m
- Versión completa
-
General3,196
-
Narración:2,635
-
Historia2,626
Ya sea que esta negatividad provenga de una relación pasada que terminó mal, un trauma infantil, un fracaso profesional o simple inseguridad, este libro te ayudará a reconocer cómo la negatividad consciente (y muchas veces inconsciente) afecta tu personalidad, tu perspectiva y tus decisiones.
-
-
Wow!
- De Amazon Customer en 22-05-19
De: Brian Tracy, y otros
-
El Alquimista
- De: Paulo Coelho
- Narrado por: Michelle Jenner
- Duración: 4 h y 26 m
- Versión completa
-
General1,046
-
Narración:912
-
Historia911
"El Alquimista" ha encontrado devotos seguidores en todo el mundo. Publicada en más de 170 países, es una de las novelas más traducidas del mundo (83 lenguas) y ha convertido a Paulo Coelho en uno de los autores más leídos de la historia.
-
-
Para Reflexionar
- De Arleth en 29-01-22
De: Paulo Coelho
-
La Teoría Let Them [The Let Them Theory]
- La clave está en soltar [The Key Is to Let Go]
- De: Mel Robbins
- Narrado por: Leyla Rangel
- Duración: 8 h y 47 m
- Versión completa
-
General234
-
Narración:222
-
Historia222
¿Qué pasaría si la felicidad, el éxito y el amor fueran más fáciles de alcanzar de lo que crees? En su nuevo audio libro, Mel Robbins, reconocida experta en motivación y mentalidad, te propone un enfoque revolucionario: aprender a soltar. Soltar las expectativas, el control, las comparaciones y el miedo para empezar a vivir plenamente.
-
-
Lo versátil de la teoría y su aplicabilidad en cualquier área
- De Alba en 27-05-25
De: Mel Robbins
-
Mi Psicólogia Me Dijo
- 110 sesiones para elegirte sin culpas y dejar de aguantar tanta M***d@
- De: Katherine Hoyer, Yulibeth R.G
- Narrado por: Mariana Dávila
- Duración: 2 h y 4 m
- Versión completa
-
General42
-
Narración:42
-
Historia42
Mi psicóloga me dijo–110 sesiones para elegirte sin culpas y dejar de aguantar tanta mierd*, no es un audiolibro para quien quiere seguir fingiendo que puede con todo. Es para quien ya no puede más. Para quien se hartó de ser fuerte todo el tiempo, de quedarse donde ya no hay espacio, de tragarse lo que siente para no le digan que exagera. Este audiolibro nace de conversaciones reales. De esas veces en que una terapeuta te mira y te dice justo lo que no querías oír, pero sabías que necesitabas. De conversaciones crudas con una psicóloga que no te deja mentirte más.
-
-
Así soy, y me amo por ello
- De Verónica G. en 23-03-26
De: Katherine Hoyer, y otros
-
Como Atraer Dinero [How to Attract Money]
- De: Joseph Murphy
- Narrado por: Adolfo Ruiz
- Duración: 1 h y 44 m
- Versión completa
-
General138
-
Narración:132
-
Historia131
Es tu derecho ser rico. Estás aquí para deleitar una vida de abundancia y plenitud, para ser feliz y libre. Por lo tanto deberías tener todo el dinero preciso para lograrlo.
-
-
Dios, la fuente que ministra nuestras necesidades.
- De Anónimo en 14-02-24
De: Joseph Murphy
-
Ya te dije adiós, ahora cómo te olvido
- De: Walter Riso
- Narrado por: Carlos Garza
- Duración: 4 h y 53 m
- Versión completa
-
General306
-
Narración:302
-
Historia302
Hay relaciones afectivas y personas que nos marcan con fuego, como si se enquistaran en nuestro ADN y en la esencia que nos define. Perderlas genera un vacío angustiante y devastador. ¿Cómo superar la ausencia de quien fue vital para nuestra vida amorosa? La premisa es la siguiente: si logras desvincularte de tu ex (o de cualquier amor imposible que ronda tu vida) de manera adecuada, podrás reinventarte como se te dé la gana. El tiempo ayuda, es cierto, pero hay que ayudarle al tiempo.
-
-
Me senti identificada plenamente
- De Lumy en 30-11-25
De: Walter Riso
-
Por si un día volvemos
- De: María Dueñas
- Narrado por: Neus Sendra
- Duración: 14 h y 14 m
- Versión completa
-
General344
-
Narración:333
-
Historia333
Hui de un crimen involuntario. Hui de los hombres que no me quisieron. Hui de una guerra. Esta es mi historia, entre España y Orán, junto al Mediterráneo. Orán. Años 20, siglo xx. En esta ciudad africana de origen árabe, pulso español y administración francesa desembarca una joven con el falso nombre de Cecilia Belmonte. En apariencia, ha cruzado el Mediterráneo para escapar de la miseria, como tantos compatriotas. Su razón, sin embargo, es más turbia. La urgencia por sobrevivir la obliga a dejarse la piel en plantaciones y lavaderos, como empleada doméstica y operaria de fábrica a destajo.
-
-
Me dio un panorama del Argel Colonial
- De Rosa Maria Mendez Garcia en 22-06-25
De: María Dueñas
-
Abraza a la niña que fuiste (La niña que fuiste)
- Sana las heridas del pasado y reconecta con tu interior [Heal the Wounds of the Past and Reconnect with Your Interior]
- De: Marta Segrelles
- Narrado por: Marta Segrelles
- Duración: 6 h y 16 m
- Versión completa
-
General112
-
Narración:109
-
Historia109
¿Qué tiene que ver mi infancia con las cosas que siento ahora? ¿De qué manera mis experiencias en esos años se relacionan con mi malestar actual? Y, sobre todo, ¿cómo puedo sanar las heridas del pasado que todavía cargo en el presente? Si alguna vez te has hecho alguna de estas preguntas, la respuesta está en tu niña interior.
-
-
Amé!
- De Me encantó mi mesa super bella y de buen material llegó en menos tiempo del previsto 😎 en 10-02-26
De: Marta Segrelles
-
El arte de la seducción [The Art of Seduction]
- De: Robert Greene
- Narrado por: Sebastian Castro Saavedra
- Duración: 23 h y 3 m
- Versión completa
-
General59
-
Narración:57
-
Historia57
El encanto, la persuasión, el talento para crear ilusiones: és-tas son tres de las muchas habilidades del seductor, ese individuo irresistible y capaz de manipular, engañar y dar placer a la vez. Llevada a la altura del arte, la seducción ha acabado con imperios, ganado elecciones presidenciales y esclavizado a las mentes más brillantes. En este libro revelador, Robert Greene expone las dos caras del acto seductor: el carácter y el proceso.
-
-
La interpretación de cada capítulo
- De Cliente de Kindle en 25-07-25
De: Robert Greene
-
El loco de Dios en el fin del mundo
- De: Javier Cercas
- Narrado por: Sergio Zamora, Javier Cercas
- Duración: 16 h y 17 m
- Versión completa
-
General341
-
Narración:328
-
Historia328
«Soy ateo. Soy anticlerical. Soy un laicista militante, un racionalista contumaz, un impío riguroso. Pero aquí me tienen, volando en dirección a Mongolia con el anciano vicario de Cristo en la Tierra, dispuesto a interrogarle sobre la resurrección de la carne y la vida eterna.
-
-
Me encantó
- De Mariolucatero en 27-11-25
De: Javier Cercas
-
Alchemised (Spanish Edition)
- No queda nadie a quien salvar
- De: SenLinYu, Ankara Cabeza Lázaro - translator, Patricia Isabel Mora Pérez - translator
- Narrado por: Marta Moreno
- Duración: 40 h y 38 m
- Versión completa
-
General251
-
Narración:244
-
Historia244
En este debut fascinante de dark fantasy, una mujer sin memoria lucha por sobrevivir en un mundo de necromancia y alquimia devastado por la guerra… y al hombre encargado de desenterrar los secretos más oscuros de su pasado. Tras una larga guerra, la nueva clase dirigente de Paladia, familias corruptas del gremio y nigromantes depravados, cuyos infames no muertos fueron clave para otorgarles la victoria, mantienen cautiva a Helena.
-
-
Espectacular
- De Anónimo en 23-02-26
De: SenLinYu, y otros
-
El arte de gastar dinero
- Pequeñas decisiones para una vida más rica
- De: Morgan Housel, Arnau Figueras Deulofeu
- Narrado por: Miguel Coll
- Duración: 6 h y 7 m
- Versión completa
-
General49
-
Narración:47
-
Historia47
El mayor retorno de una inversión no es económico, es la tranquilidad. Sin embargo, a menudo gastamos ese dinero en cosas inútiles, más preocupados por la imagen que proyectamos que por lo que realmente necesitamos. O peor, lo acumulamos con ansiedad, con miedo a gastarlo precisamente en aquello que podría mejorar nuestra vida. Explora temas como la envidia, el estatus, la identidad o la inseguridad, así como otras trampas comunes que condicionan nuestras decisiones económicas, y comparte sus lecciones clave para utilizar el dinero de una forma más sabia y reconfortante.
-
-
Me encantó. Libro muy interesante y aleccionador
- De Yaneth Garzón en 22-03-26
De: Morgan Housel, y otros
-
Nexus [Nexus: A Brief History of Information Networks from the Stone Age to AI]
- Una breve historia de las redes de información desde la Edad de Piedra hasta la IA [A Brief History of Information Networks from the Stone Age to AI]
- De: Yuval Noah Harari, Joandomènec Ros i Aragonès
- Narrado por: Luis David García Márquez
- Duración: 17 h y 50 m
- Versión completa
-
General441
-
Narración:406
-
Historia406
En Nexus, Harari contempla a la humanidad desde la amplia perspectiva de la historia para analizar cómo las redes de información han hecho y deshecho nuestro mundo. Durante los últimos 100.000 años, los sapiens hemos acumulado un enorme poder. Pero, a pesar de todos los descubrimientos, inventos y conquistas, ahora nos enfrentamos a una crisis existencial: el mundo está al borde del colapso ecológico, abunda la desinformación y nos precipitamos hacia la era de la I.A. Con todo el camino andando, ¿por qué somos una especie autodestructiva?
-
-
Asombroso, imperdible, admirable.
- De Jairo en 11-09-24
De: Yuval Noah Harari, y otros
-
Soltar para sanar
- Aprende a amarte a ti mismo y dejar ir lo que te lastima
- De: Eliana Monte, Eliana Montemayor
- Narrado por: Virtual Voice
- Duración: 5 h y 43 m
- Versión completa
-
General84
-
Narración:84
-
Historia84
¿Y si el verdadero poder no estuviera en aferrarte, sino en soltar? Este libro es una invitación profunda y valiente a liberar aquello que ya no te deja avanzar. Culpa, resentimientos, relaciones que duelen, autoexigencia agotadora... ¿cuánto más estás dispuesto a cargar? Con un lenguaje claro, cálido y poderoso, esta obra entrelaza psicología práctica, neurociencia y sabiduría emocional para ayudarte a dejar atrás lo que te lastima y recuperar tu amor propio. Cada capítulo te acompaña como un guía cercano y compasivo, mientras construyes límites saludables, transformas tu ...
-
-
Boring
- De CA en 09-12-25
De: Eliana Monte, y otros

![El Poder De La Mente Subconsciente [The Power of the Subconscious Mind] Audiolibro Por Joseph Murphy arte de portada](https://m.media-amazon.com/images/I/51dH7RbzyCL._SL320_.jpg)


![Los secretos de la mente millonaria (Narración en Castellano) [Secrets of the Millionaire Mind] Audiolibro Por T. Harv](https://m.media-amazon.com/images/I/41XaOLeWckL._SL320_.jpg)
![Proyecto Hail Mary [Project Hail Mary] Audiolibro Por Andy Weir, Javier Guerrero Gimeno arte de portada](https://m.media-amazon.com/images/I/51E+0azDcuL._SL320_.jpg)

![El poder de la disciplina [The Power of Discipline] Audiolibro Por Daniel J. Martin arte de portada](https://m.media-amazon.com/images/I/41ZVVT0l3-L._SL320_.jpg)



![Los cuatro acuerdos (Narración en Castellano) [The Four Agreements (Castilian Narration)] Audiolibro Por Janet Mills,](https://m.media-amazon.com/images/I/61ZFU2Eao7L._SL320_.jpg)

![Cómo ganar amigos e influir sobre las personas [How to Win Friends and Influence People] Audiolibro Por Dale Carnegie](https://m.media-amazon.com/images/I/51ZtBjSuKQL._SL320_.jpg)
![Las 48 leyes del poder [The 48 Laws of Power] Audiolibro Por Robert Greene arte de portada](https://m.media-amazon.com/images/I/31gjbaqsycL._SL320_.jpg)
![Si lo crees, lo creas [Believe It to Achieve It] Audiolibro Por Brian Tracy, Christina Stein arte de portada](https://m.media-amazon.com/images/I/41ibpYZWl8L._SL320_.jpg)

![La Teoría Let Them [The Let Them Theory] Audiolibro Por Mel Robbins arte de portada](https://m.media-amazon.com/images/I/61UTXUct2mL._SL320_.jpg)

![Como Atraer Dinero [How to Attract Money] Audiolibro Por Joseph Murphy arte de portada](https://m.media-amazon.com/images/I/411qcgf1h2L._SL320_.jpg)



![El arte de la seducción [The Art of Seduction] Audiolibro Por Robert Greene arte de portada](https://m.media-amazon.com/images/I/31DT9E5RKGL._SL320_.jpg)



![Nexus [Nexus: A Brief History of Information Networks from the Stone Age to AI] Audiolibro Por Yuval Noah Harari, Joandom&egr](https://m.media-amazon.com/images/I/41yBcsW74+L._SL320_.jpg)
